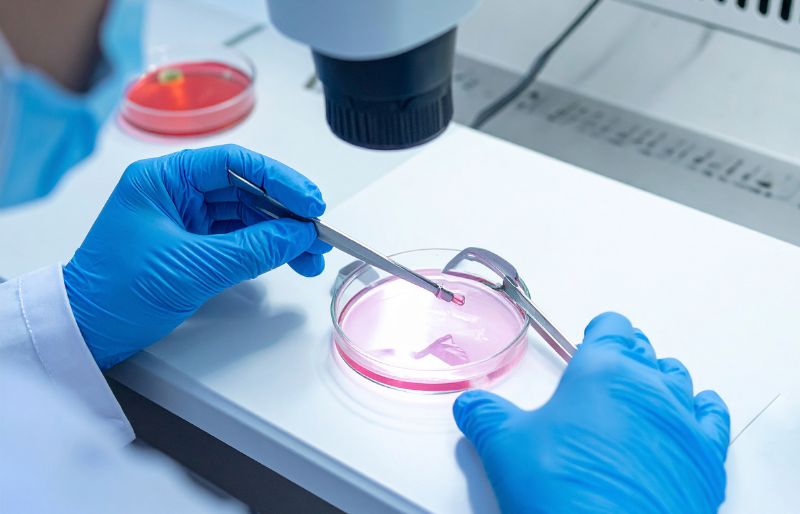

“Làm IVF có đau không?” là lo lắng của nhiều cặp vợ chồng hiếm muộn. Thực tế, cảm giác đau thường nhẹ và hoàn toàn kiểm soát được nhờ thuốc giảm đau, gây mê an toàn, cùng hướng dẫn chăm sóc sau thủ thuật. Bài viết này sẽ giải đáp chi tiết và gợi ý giải pháp giúp hành trình IVF của bạn nhẹ nhàng hơn.
Làm IVF có đau không?
Nỗi lo “Làm IVF có đau không” là băn khoăn thường gặp của nhiều cặp vợ chồng trước khi bước vào hành trình thụ tinh trong ống nghiệm. Thực tế, IVF không được coi là thủ thuật gây đau dữ dội, nhưng có thể mang lại cảm giác khó chịu nhẹ đến vừa phải ở một số giai đoạn. Mức độ đau còn phụ thuộc vào cơ địa, ngưỡng chịu đau và kỹ thuật của bác sĩ.
Hầu hết bệnh nhân trải qua IVF đều cho rằng các thủ thuật không đau dữ dội như họ tưởng tượng, mà chủ yếu chỉ gây cảm giác căng tức, hơi nhói hoặc khó chịu thoáng qua.
Yếu tố ảnh hưởng đến cảm giác đau khi làm IVF
Điều này phụ thuộc vào nhiều yếu tố, bao gồm:
- Cơ địa và ngưỡng chịu đau của từng người.
- Tay nghề bác sĩ và kỹ thuật hỗ trợ.
- Trang thiết bị, phương pháp gây mê/giảm đau hiện đại.
- Tâm lý của người bệnh: lo lắng nhiều có thể làm cảm giác đau bị phóng đại.
Cảm giác đau ở từng giai đoạn của IVF
Nếu ba mẹ đang lo lắng “làm IVF có đau không?”, câu trả lời là đa số trường hợp không đau dữ dội, mà chủ yếu là cảm giác khó chịu nhẹ đến vừa phải. Tuy nhiên, mức độ cảm nhận còn tùy cơ địa và giai đoạn điều trị. Dưới đây là phân tích chi tiết:
Kích thích buồng trứng
Trong khoảng 10 – 12 ngày, bệnh nhân cần tiêm hormone để buồng trứng sản xuất nhiều trứng trưởng thành.
- Kim tiêm rất nhỏ nên hầu hết chỉ gây nhói nhẹ trong vài giây.
- Do phải tiêm nhiều lần/ngày, có thể xuất hiện đau nhức hoặc bầm nhẹ tại vị trí tiêm.
- Thuốc hormone có thể gây chuột rút, đầy hơi, đau đầu hoặc thay đổi tâm trạng, tương tự như khó chịu trong kỳ kinh nguyệt.
Chọc hút trứng

Đây là thủ thuật khiến nhiều chị em lo sợ nhất, nhưng trên thực tế:
- Người bệnh được gây mê toàn thân hoặc tiền mê, nên không cảm thấy đau trong quá trình chọc hút.
- Sau thủ thuật, có thể gặp chuột rút bụng dưới, tiết dịch âm đạo hồng nhẹ, kéo dài 1 – 2 ngày, đôi khi đến 1 tuần.
- Mức độ khó chịu thường được mô tả giống như cơn đau bụng kinh nhẹ.
Chuyển phôi
- Thủ thuật này diễn ra nhanh, chỉ mất vài phút.
- Cảm giác thường là khó chịu nhẹ, giống như khi làm xét nghiệm Pap smear.
- Một số trường hợp căng thẳng có thể được cho thuốc an thần đường uống để giảm lo lắng.
Sử dụng Progesterone sau chuyển phôi
Để hỗ trợ sự làm tổ của phôi, bác sĩ thường chỉ định progesterone dạng đặt hoặc tiêm.
- Thuốc đặt/gel âm đạo: ít gây đau, dễ sử dụng.
- Tiêm gốc dầu: có thể gây đau nhức tại chỗ tiêm nhưng vẫn kiểm soát được.
Làm IVF bao lâu thì hết đau?
Nỗi lo “làm IVF có đau không” thường đi kèm với thắc mắc đau sẽ kéo dài bao lâu. Thực tế, hầu hết các bước trong quy trình IVF chỉ gây khó chịu nhẹ đến vừa phải và cảm giác này thường không kéo dài lâu. Nhìn chung, sau thủ thuật chính, cảm giác này thường giảm nhanh trong vài ngày và ít khi kéo dài hơn 1 tuần.
| Giai đoạn | Thời gian kéo dài |
| Kích thích buồng trứng | Suốt 10 – 12 ngày tiêm thuốc |
| Chọc hút trứng | Thường 1 – 2 ngày, hiếm khi đến 1 tuần |
| Chuyển phôi | Thoáng qua, hết sau vài giờ đến 1 ngày |
| Tiêm Progesterone (sau chuyển phôi) | Lặp lại mỗi lần tiêm, kéo dài suốt giai đoạn điều trị |
Tóm lại, nếu bạn thắc mắc “làm IVF có đau không và bao lâu thì hết đau”, thì câu trả lời là: hầu hết cảm giác đau chỉ tạm thời và biến mất trong vài ngày, ngoại trừ giai đoạn tiêm hormone hoặc progesterone có thể kéo dài hơn do thực hiện nhiều lần.
Giải pháp giảm đau an toàn khi làm IVF
Nhiều ba mẹ đang băn khoăn làm IVF có đau không sẽ yên tâm hơn khi biết rằng có rất nhiều phương pháp giảm đau an toàn, được áp dụng linh hoạt trong từng giai đoạn. Dưới đây là các giải pháp thường được bác sĩ chỉ định.
Giảm đau trước và trong thủ thuật
Để giúp bệnh nhân thoải mái ngay từ đầu, các giải pháp giảm đau trước và trong thủ thuật được áp dụng phổ biến gồm:
- Thuốc giảm đau nhẹ hoặc gây tê tại chỗ: hỗ trợ tốt khi tiêm hormone hoặc làm thủ thuật nhỏ.
- Gây mê/gây tê toàn thân nhẹ: được áp dụng trong chọc hút trứng, giúp hầu như không cảm thấy đau.
- Theo dõi sát bởi bác sĩ gây mê: đảm bảo an toàn tối đa và hạn chế rủi ro.
Giải pháp sau thủ thuật

Sau khi hoàn thành các thủ thuật, người bệnh thường được hướng dẫn những biện pháp giảm đau an toàn như:
- Thuốc giảm đau kê đơn hoặc OTC: làm dịu nhanh cơn đau bụng nhẹ và chuột rút.
- Chườm ấm, nghỉ ngơi hợp lý: giúp giảm căng tức và co thắt bụng.
- Bổ sung nước và chế độ ăn nhẹ: hạn chế đầy hơi, khó chịu sau khi dùng hormone.
Giải pháp không dùng thuốc
Ngoài thuốc, nhiều phương pháp hỗ trợ tự nhiên cũng được khuyến khích để giảm khó chịu trong hành trình IVF:
- Thư giãn và hít thở sâu: giúp giải tỏa căng thẳng, giảm cảm giác đau.
- Massage nhẹ, châm cứu hoặc yoga sinh sản: cải thiện tuần hoàn và mang lại sự dễ chịu.
- Tư vấn tâm lý và hỗ trợ tinh thần: giúp kiểm soát lo lắng – yếu tố thường làm đau đớn trở nên rõ rệt hơn.
Khi nào cần báo bác sĩ ngay
Mặc dù phần lớn cơn đau chỉ ở mức nhẹ, nhưng bạn cần liên hệ ngay với bác sĩ điều trị IVF giỏi nếu xuất hiện các dấu hiệu bất thường sau:
- Đau bụng dữ dội kéo dài.
- Ra máu nhiều sau thủ thuật.
- Sốt cao, khó thở hoặc sưng phù.
Tư vấn điều trị IVF tại Bệnh Viện Sài Gòn
Khi tìm hiểu về làm IVF có đau không hay tỷ lệ thành công của phương pháp này, nhiều cặp vợ chồng thường quan tâm đến nơi điều trị uy tín và có dịch vụ chăm sóc toàn diện. Bệnh Viện Sài Gòn là một trong những địa chỉ được đánh giá cao tại TP.HCM, mang lại cơ hội làm cha mẹ cho hàng nghìn gia đình.
Dịch vụ điều trị nổi bật
Bệnh viện cung cấp đa dạng dịch vụ nhằm tối ưu cơ hội có con cho các cặp vợ chồng:
- Thụ tinh trong ống nghiệm (IVF): Sử dụng công nghệ PIEZO ICSI hiện đại, hỗ trợ thụ tinh trứng với tinh trùng trong môi trường phòng lab đạt chuẩn.
- Bơm tinh trùng vào buồng tử cung (IUI): Giải pháp ít xâm lấn, giúp tăng cơ hội thụ thai tự nhiên cho nhiều trường hợp.
- Gói thai sản trọn gói: Theo dõi sức khỏe mẹ bầu từ giai đoạn mang thai đến khi sinh, mang lại sự an tâm toàn diện.
Tỷ lệ thành công IVF tại Bệnh Viện Sài Gòn

Tỷ lệ IVF thành công tại Bệnh Viện Sài Gòn dao động trung bình từ 45% – 65%. Đặc biệt, ở một số trường hợp được áp dụng các kỹ thuật hỗ trợ tiên tiến, tỷ lệ này có thể vượt trên 70%, nhất là đối với những bệnh nhân trẻ tuổi hoặc có sức khỏe sinh sản tốt. Đến nay, bệnh viện đã ghi nhận hơn 500 ca IVF thành công, đồng thời nhận được sự tin tưởng của hơn 100.000 người bệnh và đạt mức hài lòng lên tới 96%.
Đội ngũ y bác sĩ chuyên môn cao
Một yếu tố quan trọng khi bệnh nhân tìm hiểu làm IVF có đau không chính là tay nghề bác sĩ. Bệnh Viện Sài Gòn quy tụ đội ngũ hơn 100 y bác sĩ và điều dưỡng, trong đó có nhiều chuyên gia hàng đầu:
- BSCKII Hồ Cao Cường: Gần 30 năm kinh nghiệm, chuyên sâu về hiếm muộn, IVF và phẫu thuật nội soi.
- BSCKII Lý Thái Lộc: Cố vấn chuyên môn, gần 40 năm kinh nghiệm Sản phụ khoa, 28 năm trong hỗ trợ sinh sản.
- BSCKII Lê Huy Bình: Trưởng khoa Sản phụ, đã có 15 năm kinh nghiệm trong lĩnh vực sản phụ khoa.
Cơ sở vật chất và dịch vụ hỗ trợ
Bệnh viện đầu tư hệ thống phòng lab IVF chuẩn quốc tế, trang thiết bị hiện đại phục vụ chăm sóc sau thủ thuật. Ngoài ra, còn có nhiều dịch vụ hỗ trợ:
- Khám ngoài giờ (17:00 – 19:00, Thứ 2 – 6; cả cuối tuần theo lịch hẹn).
- Đặt lịch hẹn trực tiếp với bác sĩ mong muốn.
- Hỗ trợ tài chính: Trả góp 0% lãi suất qua thẻ tín dụng một số ngân hàng.
Thông tin liên hệ:
- Địa chỉ: 87 Lý Chiêu Hoàng, Phường Bình Phú, TP Hồ Chí Minh
- Hotline: Thứ Hai đến Thứ Bảy: 7:00 – 16:30 và Chủ Nhật: 7:00 – 11:30
- Liên hệ: 0376.003.600
- Email: lienhe@benhvienhiemmuonsaigon.vn
Làm IVF có đau không? Thực chất, IVF chỉ gây khó chịu nhẹ chứ không quá đau và đều có thể kiểm soát bằng thuốc giảm đau, gây tê/gây mê an toàn cùng các biện pháp tự nhiên như chườm ấm, nghỉ ngơi và giữ tâm lý thoải mái. Với hỗ trợ y khoa hiện đại, hành trình IVF trở nên nhẹ nhàng hơn nhiều. Liên hệ ngay Bệnh Viện Sài Gòn để được tư vấn chi tiết nhé!
Nguồn tham khảo:
https://www.ovoria.com/blog/ivf/is-it-painful
https://www.ccrmivf.com/blog/is-ivf-painful/
https://www.novaivffertility.com/fertility-help/is-ivf-painful/



















